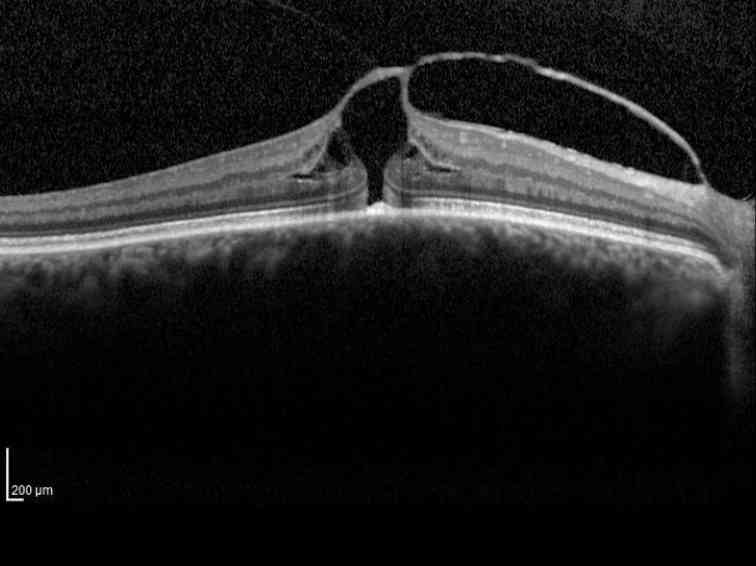
dbottom

Cardiff based Independent Optometrists providing frontline primary eyecare including routine sight tests, contact lens consultations, assessments for refractive surgery, occupational optometry and emergency eye care. Visit or friendly and efficient practices in Roath Park and North Cardiff.

About Medi-Optics
Founded by Dr David Woolf in 2004, Medi-Optics Opticians moved to its current location in Roath Park in 2007. In 2015 Dr Woolf acquired John O’Connor Davies Optometrists in Llanishen. O’Connor Davies is an independent Optometrist with a long pedigree: both John, and his father Paddy before him, have been involved in optics for nearly fifty years.
Our Philosophy
In an age of faceless conglomerate corporate organisations, many folk are increasingly favouring community-based, artisan solutions to many of their life choices.
The fundamental ethos of both O’Connor Davies and Medi-Optics is the same. Namely, independent optometrists providing a caring, compassionate, quality, community-based eye care service. The two practices have now been amalgamated to form Medi-Optics Roath Park and Medi-Optics North Cardiff.

Our sites
The two practices have now been amalgamated to form Medi-Optics Roath Park and Medi-Optics North Cardiff.
Roath Park (029) 2076 4963
12 Maryport Road, Roath Park, Cardiff, CF23 5JX
Fax: (029) 2075 8703
Monday – usually closed
(occasionally appointments are available)
Tuesday – Friday: 9.30am – 5.00pm
Saturday: 9.30am – 1.00pm
North Cardiff (029) 2075 4659
3 Thornhill Road, Llanishen, Cardiff, CF14 6PD
Fax: (029) 2076 5137
Monday, Tuesday and Thursday – 9.15am -5.00pm
Wednesday, – 9.30am -4.30pm
Friday – 9.15am -4.30pm
Saturday – 9.15am-1pm
Sunday – Closed
Appointments
At Medi-Optics Opticians we offer 30 minute appointments in a friendly, relaxed environment. A full range of optometric and dispensing services are available, including spectacles, contact lenses, assessments and referral for refractive surgery, occupational/safety eyewear, referral for cataract surgery and glaucoma co-management.
Please contact your nearest Medi-Optics site above to make an appointment.

Our Optometrists
All of the Optometrists working at Medi-Optics are accredited WECS practitioners. Some of them hold higher professional qualifications in Optometry such as the Professional Certificate in Glaucoma and the Postgraduate Certificate in Clinical Optometry.
High resolution 3D retinal imaging at Medi-Optics
The Medi-Optics group is at the cutting edge of modern optometric eye care, employing the very latest technology. Recently we have installed a Heidelberg ‘Spectralis’ ocular coherence tomography (OCT) system. This can record longitudinal high resolution 3-dimensional images of the retina, macula, optic disc, anterior chamber, iridocorneal angle and cornea and is ideal for monitoring a number of progressive eye diseases such as macular degeneration, diabetes and glaucoma. The ‘Spectralis’ OCT is the system selected by NASA for use on the International Space Station when assessing the eye care of their Astronauts.
John O’Connor Davies and Dr Woolf were amongst the first cohort of Optometrists who signed up for the Welsh Eye Care Scheme (WECS). This scheme empowers Optometrists in the community to manage a wide variety of acute and chronic eye conditions that previously would have requited referral into the Hospital Eye Service. All of the Optometrists working at Medi-Optics are accredited WECS practitioners. Some of them hold higher professional qualifications in Optometry such as the Professional Certificate in Glaucoma and the Postgraduate Certificate in Clinical Optometry.

Dr David A Woolf BSc, PhD, MCOptom, FInstP, Prof Cert Glauc
Education: St Mary Redcliffe & Temple School, Bristol; University College Cardiff (University of Wales); Cardiff University; College of Optometrists. BSc (Physics 1986), PhD (Physics 1990), BSc (Optometry & Vision Sciences 1998); Professional Certificate in Glaucoma (College of Optometrists), 2012; Postgraduate Certificate in Clinical Optometry (Cardiff University), 2016; Member of the Institute of Physics, 1991; Chartered Physicist, 1991; Member of the College of Optometrists, 1999; Fellow of the Institute of Physics, 2003; Chartered Scientist, 2004; member and occasional chairman of the Institute of Physics Fellowship Application Panel, 2003 – present; Fellow Royal Society of Medicine, 2017; Senior Fellow, Newman Hall (Cardiff University Catholic Chaplaincy), 2017; elected to the Freedom of the Worshipful Company of Spectacle Makers, 2018; appointed a Freeman of the City of London, 2018; “clothed as of the Livery” - admitted as a Liveryman of the Worshipful Company of Spectacle Makers, 2018.
Publications: 86 papers in international learned journals in solid state physics, surface physics, molecular beam epitaxy and semiconductor physics.
Career: Post-Doctoral Research Fellow and part-time Lecturer (Physics), 1987 - 1995. Ophthalmic Optician, 1999 – present. Founder and Clinical Director of Medi-Optics Opticians, Cardiff, 2004 - present.
Recreation: photography; heraldry; reading; off-road driving; music; connoisseur of micro-distillery gin; the study of iconography; aviation – for a number of years Medi-Optics sponsored the last flying Vulcan bomber, XH558.
Charitable work: Dr Woolf heads up in Wales the Military & Hospitaller Order of St Lazarus of Jerusalem (MHOStLJ), one of the oldest orders of chivalry, which raises funds for the alleviation of leprosy and other such diseases. Under Dr Woolf’s direction, MHOStLJ Wales has run a number of projects: the establishment of a telemedicine scheme with the Samburu Trust in Kenya; support for the Orbis Flying Eye Hospital; equipment for ‘Leaves of Hope’ orphanage in Belarus; an emergency appeal to supply medical aid during the draught in Samburu, Kenya; an auto blood analyser for a leprosy clinic in Kolkata; support for various on-going projects with the Leprosy Mission in Danja, Kenya; support for the Army Benevolent Fund; and also an annual student bursary for a final year medical student’s elective study programme.
Mrs Amanda Wallen BSc, MCOptom
Graduated from the University of Wales (Cardiff) with a BSc in Optometry and Vision Science in 1994. Membership of the College of Optometrists (MCOptom) in 1995. Accredited Diabetic Screener in 1999. Accredited as a Welsh Eye Care Scheme practitioner in 2008.
Interests: Strength and weight training; travel, especially in Greece; and reading crime novels.
Mrs Kate Evans
Initially started working in optics as an Optical Assistant, aged 19 years. In 2003 enrolled with the Association of British Dispensing Opticians to study to become a Dispensing Optician. Qualified in 2006 as a Fellow of the Association of British Dispensing Opticians (FBDO) in 2006. On returning to work after having two children I wanted to further my career in optics and was accepted to study Optometry. I graduated from Cardiff University in 2013 with a BSc(Hons) in Optometry and Vision Science. My pre-registration training was undertaken with Mr John O’Connor-Davies at O’Connor-Davies Optometrists (now Medi-Optics North Cardiff). I qualified a Member of the College of Optometrists (MCOptom) in 2014. I specialise in the fitting and aftercare of complex contact lenses and have an interest in paediatric optometry and caring for patients with learning disabilities. Outside of work I enjoy board games, baking and spending time with my family.
Mr Darran Stuckey BSc, MCOptom, Prof Cert Glauc
Graduated from the Bradford University with a BSc in Optometry in 2009. Membership of the College of Optometrists (MCOptom) in 2011. Accredited as a Welsh Eye Care Scheme practitioner. Professional Certificate in Glaucoma (College of Optometrists) in 2014. Postgraduate Diploma in Clinical Optometry (Cardiff University) in 2015.
Interests: rugby and travel.


